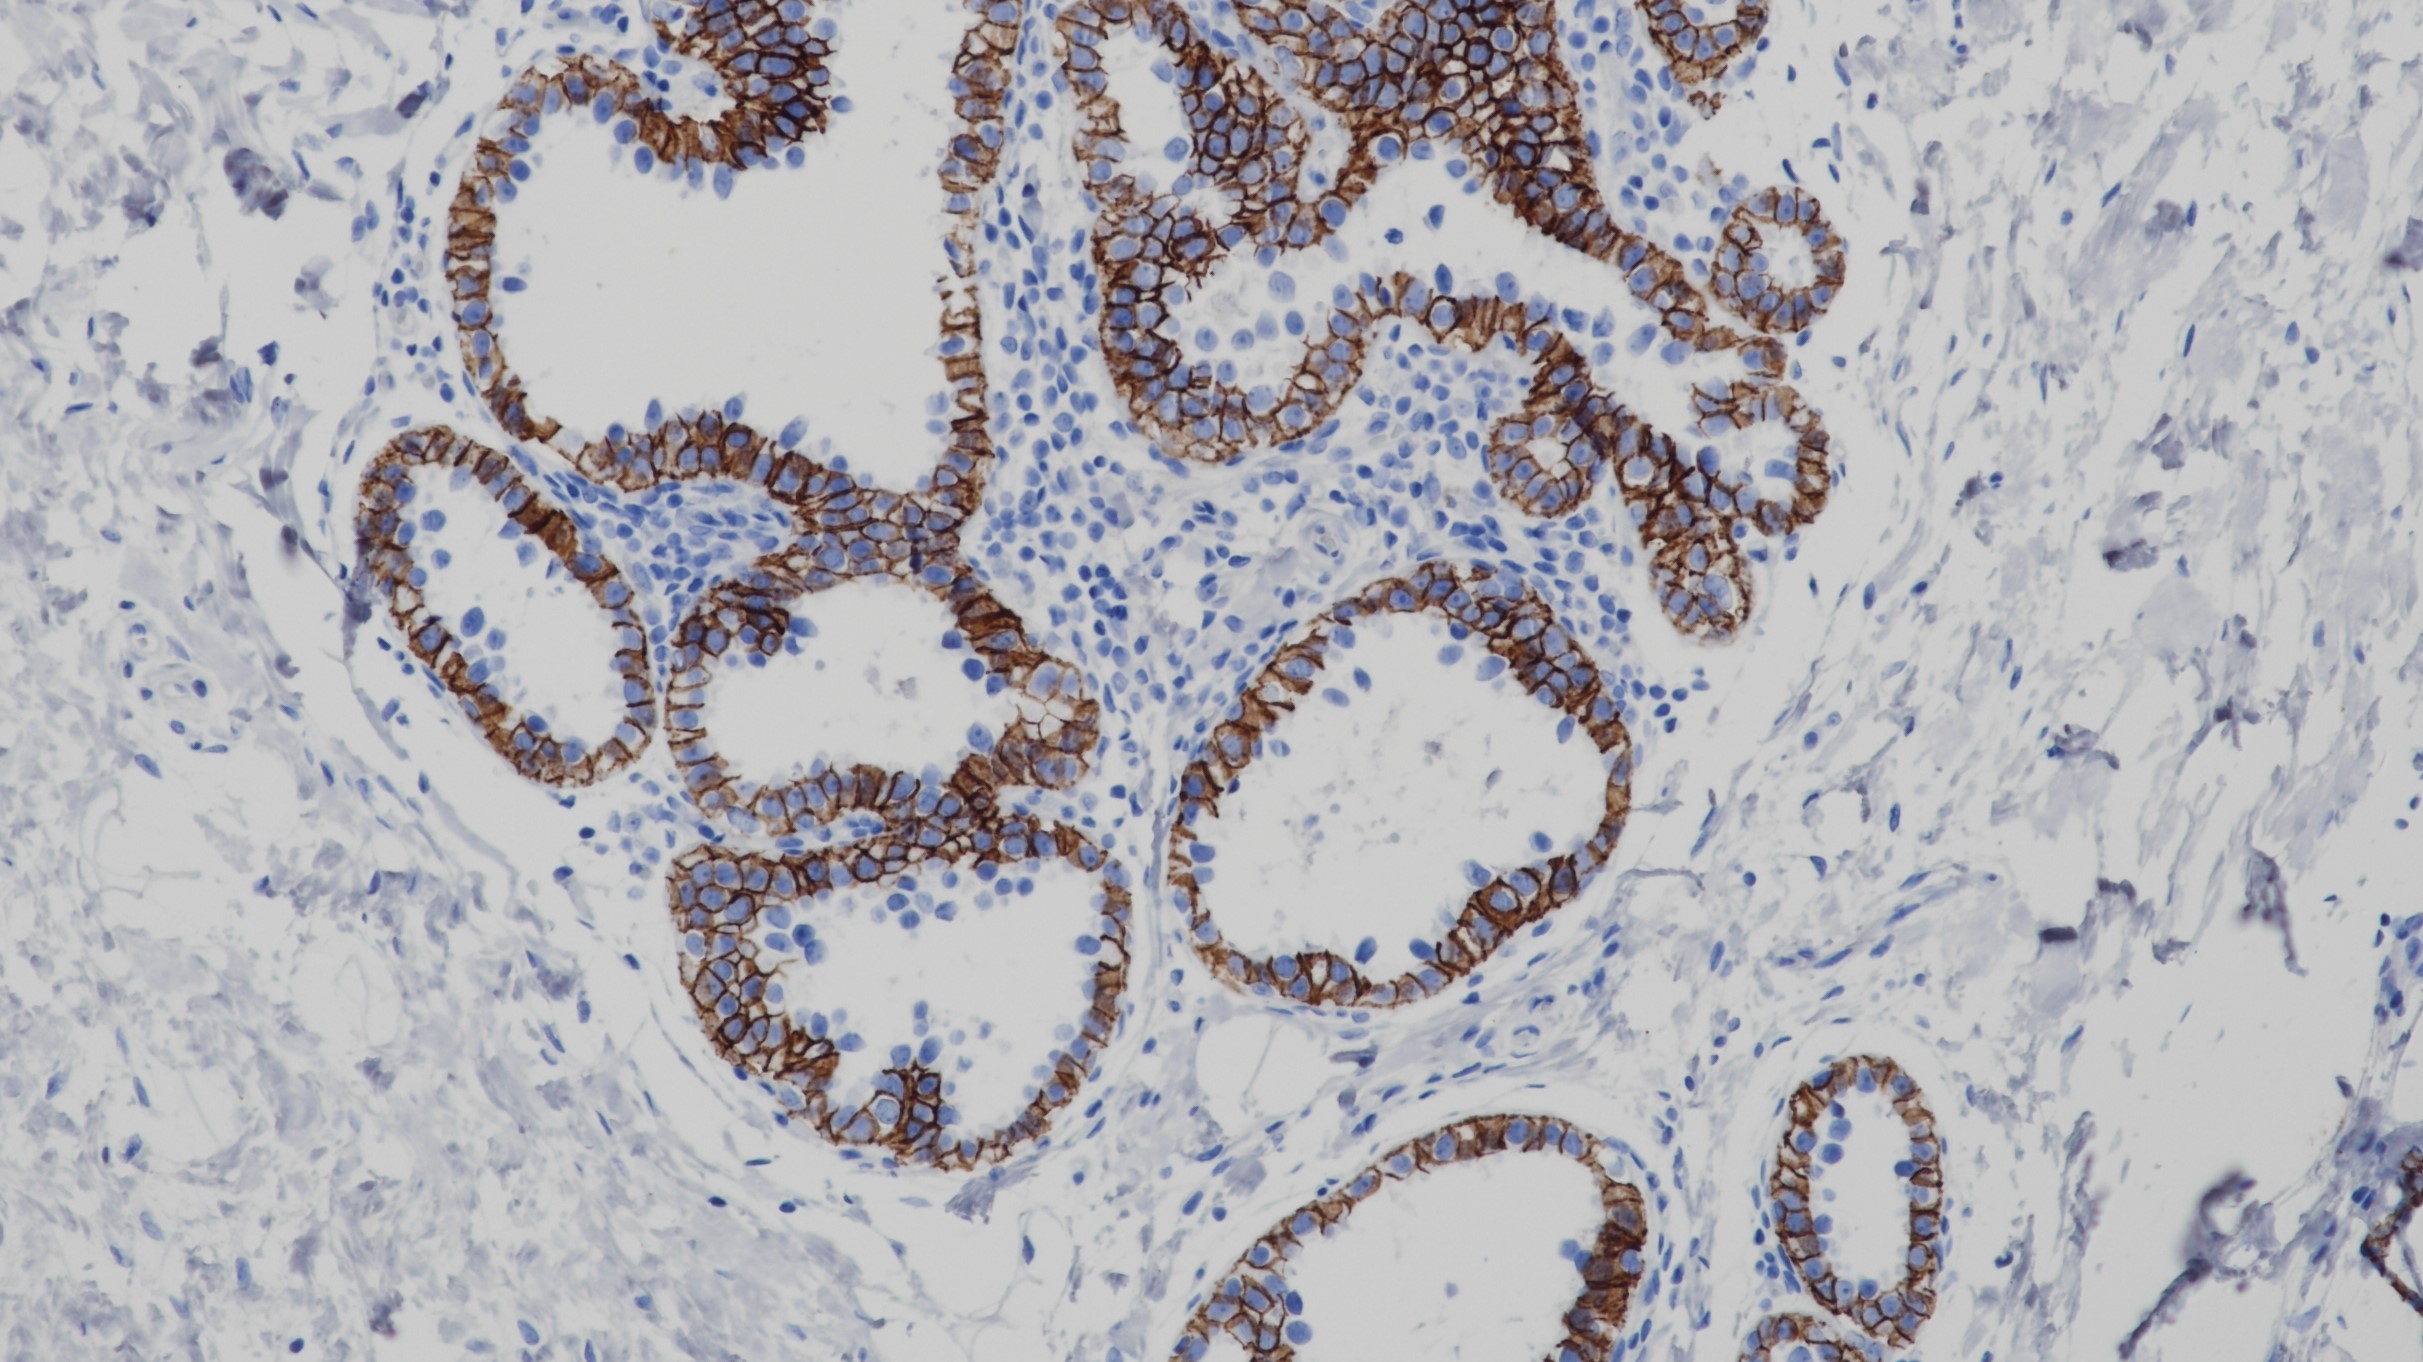
乳腺p120(BP6075)染色

1. Reynolds A B , Roczniak-Ferguson A . Emerging roles for p120-catenin in cell adhesion and cancer[J]. Oncogene, 2004, 23(48):7947-7956.
2. Mayerle J , Friess H , Markus W Büchler, et al. Up-regulation, nuclear import, and tumor growth stimulation of the adhesion protein p120 in pancreatic cancer[J]. Gastroenterology, 2003, 124(4):949-960.
3. 中华医学会.《临床技术操作规范·病理学分册》.人民军医出版社,2004.